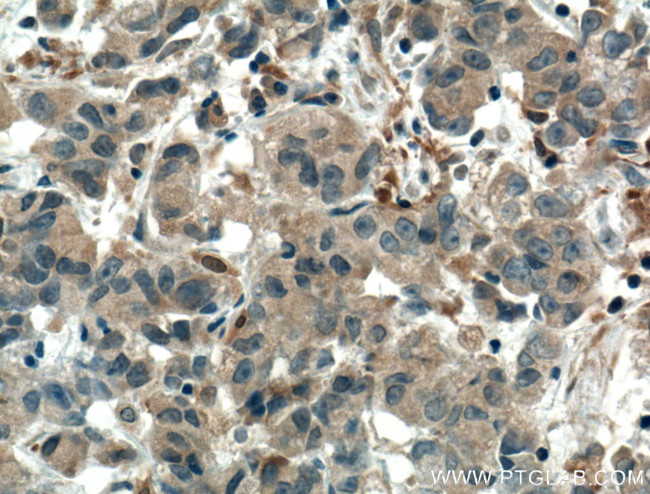
SULT1C2 Antibody in Immunohistochemistry (Paraffin) (IHC (P))

Search
Proteintech
SULT1C2 Polyclonal Antibody
{{$productOrderCtrl.translations['antibody.pdp.commerceCard.promotion.promotions']}}
{{$productOrderCtrl.translations['antibody.pdp.commerceCard.promotion.viewpromo']}}
{{$productOrderCtrl.translations['antibody.pdp.commerceCard.promotion.promocode']}}: {{promo.promoCode}} {{promo.promoTitle}} {{promo.promoDescription}}. {{$productOrderCtrl.translations['antibody.pdp.commerceCard.promotion.learnmore']}}
产品信息
10662-1-AP
种属反应
已发表种属
宿主/亚型
分类
类型
抗原
偶联物
形式
浓度
规格
纯化类型
保存液
内含物
保存条件
运输条件
产品详细信息
Immunogen sequence: MALTSDLGK QIKLKEVEGT LLQPATVDNW SQIQSFEAKP DDLLICTYPK AGTTWIQEIV DMIEQNGDVE KCQRAIIQHR HPFIEWARPP QPSGVEKAKA MPSPRILKTH LSTQLLPPSF WENNCKFLYV ARNAKDCMVS YYHFQRMNHM LPDPGTWEEY FETFINGKVV WGSWFDHVKG WWEMKDRHQI LFLFYEDIKR DPKHEIRKVM QFMGKKVDET VLDKIVQETS FEKMKENPMT NRSTVSKSIL DQSISSFMRK GTVGDWKNHF TVAQNERFDE IYRRKMEGTS INFCMEL (1-296 aa encoded by BC005353)
靶标信息
Sulfotransferase enzymes catalyze the sulfate conjugation of many hormones, neurotransmitters, drugs, and xenobiotic compounds. These cytosolic enzymes are different in their tissue distributions and substrate specificities. The gene structure (number and length of exons) is similar among family members. SULT1C2 belongs to the SULT1 subfamily, responsible for transferring a sulfo moiety from PAPS to phenol-containing compounds. SULT1C2 belongs to a SULT subfamily that shows specificity for hydroxyarylamines. SULT1C2 catalyzes the sulfonation of p-nitrophenol and N-hydroxy-2-acetylaminofluorene, but not dopamine.
仅用于科研。不用于诊断过程。未经明确授权不得转售。
生物信息学
蛋白别名: 1C member 4; humSULTC2; MGC149521; MGC34422; rSULT1C2; ST1C2; Sulfotransferase 1C1; Sulfotransferase 1C2; sulfotransferase family, cytosolic, 1C, member 1; sulfotransferase family, cytosolic, 1C, member 2; Sulfotransferase K1; SULT1C#1; unnamed protein product
基因别名: 1810008N17Rik; humSULTC2; ST1C1; ST1C2; SULT1C1; SULT1C2; Sultk1
UniProt ID: (Human) O00338, (Mouse) Q9D939, (Rat) Q9WUW8
Entrez Gene ID: (Human) 6819, (Mouse) 69083, (Rat) 171072